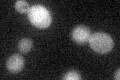
YMR288W
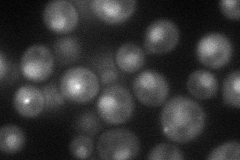
YMR288W
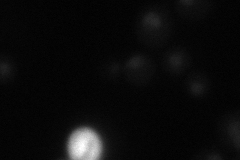
YMR288W
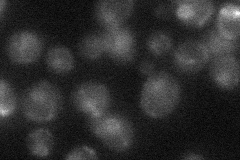
YMR288W
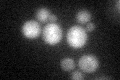
YMR288W
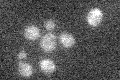
YMR288W

View description
U2-snRNP associated splicing factor that forms extensive associations with the branch site-3' splice site-3' exon region upon prespliceosome formation; similarity to the mammalian U2 snRNP-associated splicing factor SAP155
Localization:
Intensity:
Fold change:
Significance:
-
C’ GFP library in SD
below threshold15.93 -
N' NOP1pr-GFP in SD
punctate,nucleus58.1715 -
N' TEF2pr-mCherry in SD
nucleus16.0614 -
N' NATIVEpr-GFP in SD
nucleus19.745 -
N' TEF2pr-VC and Cyto-VN in SD

#N/A0 -
C’ GFP library in SD+DTT
cytosol17.631.1No -
C’ GFP library in SD+H2O2

cytosol17.251.08No -
C’ GFP library in Starvation Media
cytosol15.931No -
C’ GFP library on the background of Pup2-DaMP

below threshold -
C’ GFP library on the background of CCT mutant

below threshold16.76691.05232No
